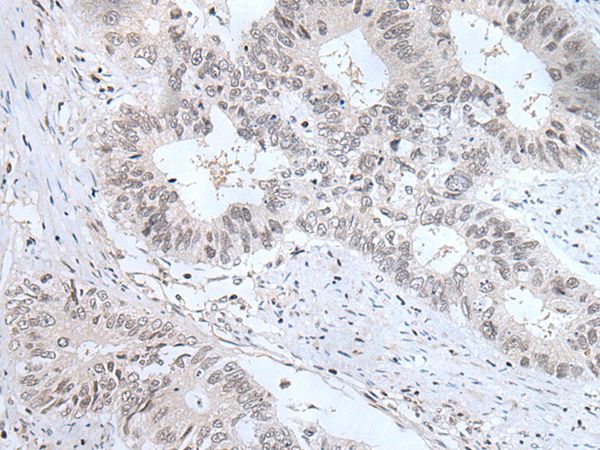
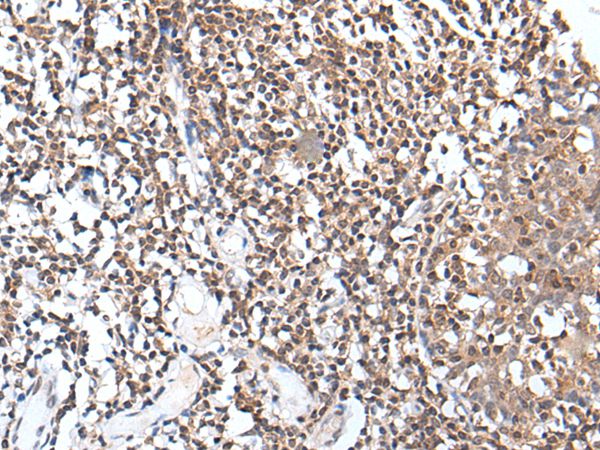

-
分类: 科研抗体货号: P43470别名: WEE1A; WEE1hu应用: WB,IHC反应种属: Human,Mouse,Rat
-
分类: 科研抗体货号: P43452别名: E2F-5应用: WB,IHC反应种属: Human,Mouse
-
分类: 科研抗体货号: P43469别名: 45170应用: WB,IHC反应种属: Human
-
分类: 科研抗体货号: P43451别名: SSC1; AQP-9; HsT17287应用: WB,IHC反应种属: Human
-
分类: 科研抗体货号: P43468别名: TCF3; TCF-3应用: WB,IHC反应种属: Human
-
分类: 科研抗体货号: P43450别名: C3-C5; METH1应用: IHC反应种属: Human
-
分类: 科研抗体货号: P43467别名: OF; XDP; BA2R; CCG1; CCGS; DYT3; KAT4; P250; NSCL2; TAF2A; N-TAF1; TAFII250; DYT3/TAF1; TAFII-250; TAF(II)250应用: WB,IHC反应种属: Human,Mouse
-
分类: 科研抗体货号: P43449别名: IRP; INT1L1应用: WB,IHC反应种属: Human
-
分类: 科研抗体货号: P43448别名: D52; N8L; PC-1; PrLZ; hD52应用: WB,IHC反应种属: Human
-
分类: 科研抗体货号: P43466别名: EVI16应用: IHC反应种属: Human

鄂公网安备42018502007531号
鄂公网安备42018502007531号

